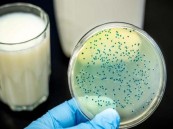
قد تنقل المرض للإنسان.. 5 حيوانات عرضة للإصابة بـ “الحمى المالطية”

شؤون الحرمين” تتيح تطبيق “تنقل” لحجز العربات الكهربائية لضيوف بيت الله الحرام
أتاحت الهيئة العامة للعناية بشؤون المسجد الحرام والمسجد النبوي خدمة حجز العربات الكهربائية من خلال تطبيق "تنقل" والموجود على متاجر الأجهزة الذكية، حيث يتيح التطبيق للراغبين من ضيوف بيت الله الحرام حجز العربات الكهربائية؛ ليتمكنوا من الطواف والسعي داخل البيت ...
الزيارات 719